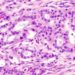
Técnica reverte agressividade do câncer de pâncreas

Depois de quase cinco anos, desde uma virada na vida de Gru, em Meu malvado favorito, a mais nova aventura do estúdio Illumination, impulsionada pelo veterano produtor Chris Meledandri, desenterra um colorido passado para o suavemente mal-humorado protagonista Gru. A premissa setentista é o que move Minions 2: A origem de Gru, a partir de hoje na telona.
Aos 11 anos, Gru, ainda numa versão “pivetinho”, travará o primeiro contato com as “batatinhas de macacão”, como são denominados os minions. Já nos bancos da escola fundamental, enquanto colegas de classe são encorajados a serem médicos, Gru externa a vontade de ser “um supervilão”. A senha para chegar lá existe e, na trama, é verbalizada por You´re no good, frase que deve ser dita, antes de uma entrevista (secreta) para Gru suprir uma vaga em aberto do mafioso grupo Sexteto Sinistro.
You´re no good, por sinal, é uma das músicas, ao lado de sucessos como Born to be alive, Keep it comin´love e Goodbye to love, que integram a ótima trilha assinada pelo produtor Jack Anttonoff. Os elementos musicais são tantos no filme, a ponto de incluírem tortura (a partir de música), mensagens cifradas em discos executados ao contrário e segredos em cabines sonoras de departamentos de vendas.
Um vilão envelhecido, que atende por Willy Kobra, sofre um processo de sabotagem da chamada “próxima geração” dos colegas vilões e se torna mais do que um ídolo para Gru. Há peso no enredo para situações de descarte profissional e demissão, mas que são prontamente criticadas pelo roteiro.
No filme comandado por Kyle Balda e codirigido por Brad Ableson (Os Simpsons) e Jonathan del Val (Pets — A vida secreta dos bichos) a idolatria é um dos agentes motores. A própria displicente mãe de Gru deposita todas as fichas na admiração desmedida por um novo guru, enquadrado em comportamentos dos anos de 1970.
Tratados por Gru como “miniparentes”, os ingênuos e despreparados minions conseguem extrair graça até mesmo de falso coro fúnebre. No começo da trama, eles surgem em forma de exército, como paramentados lutadores dourados. Mais adiante, os ferozes personagens amarelados aprendem kung fu, depois de instruídos por uma exigente mestra que desperta a “fera interior” de cada um. Mas o filme perde muito da graça, quando os minions se transmutam em frango, bode e galinha.
Vistos como espécie de capangas, minions como Stuart, Kevin e Bob tentam, a todo custo, comprovar a lealdade suprema junto ao mestre Gru. Os ajudantes persistentes acumulam pequenos desastres e trapalhadas, na jornada para livrar a cara do “minichefe” (o codinome de Gru) que concentra a maior parte da ação em São Francisco, mais precisamente num dos bairros Chinatown mais estabelecidos entre os norte-americano.
Pelos ares
Folheando, de última hora, um manual de voo, uma endiabrada versão de minions que tripula, sem perícia, uma viagem aérea até São Francisco rouba a cena, ao som de uma valsa de Strauss. Na base da subversão, um piloto dorme (diante da facilidade do piloto automático), outro sofre os enjoos pelos efeitos da gravidade e um, metido a comissária, radica amendoim para os passageiros.
Aliado do trio de minions, o confuso Otto carrega uma joia (a famosa Pedra do Zodíaco) que desperta o quinteto de contraventores liderado por Donna Disco, e que traz criminosos como Irmã Chaco, Punho de Aço, Svengança e Jean Garra. Pouco a pouco, as leves traquinagens de Gru, que incluíam o consumo de sorvete, em frente a esforçados malhadores de academia, se intensificam. Fica a dúvida de ele completar (ou não) o ciclo que o posicionará como tremendo expoente do mal.